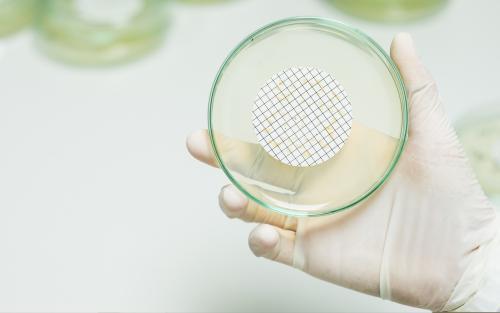
Photograph of Legionella Testing

Water hygiene and microbiological control are essential for safeguarding health and maintaining regulatory compliance across a wide range of environments. From leisure facilities and schools to healthcare sites and shipping vessels, microbiological testing verifies that water systems remain safe, clean, and free from harmful pathogens such as Legionella and Pseudomonas aeruginosa.
As a UKAS-accredited testing laboratory (No. 1227), Envirochem undertakes comprehensive microbiological testing and analysis, supported by decades of experience in environmental compliance, chemical testing, and occupational hygiene. Integrating our extensive range of tests into your water quality monitoring programme allows you to quickly detect changes, determine whether quality has been compromised, and effectively implement the right corrective measures.
Our work extends beyond routine analysis to include expert interpretation and tailored advice, ensuring that all results are backed by clear recommendations. We support clients throughout the South Coast and nationwide, delivering accurate results that help you maintain water quality, meet statutory obligations, and protect your clients and their reputations. Whether you manage facilities, oversee water quality, or maintain leisure spaces like swimming pools, our team can help you identify the right sampling approach and testing frequency to meet your legal and operational requirements.
Our Services
Why Choose Envirochem?
- UKAS-Accredited Analysis: Microbiological testing is undertaken in our in-house UKAS-accredited testing laboratory (No. 1227) where within scope, ensuring full traceability and confidence in reported results.
- Technical Expertise: Our team combines laboratory precision with field experience, offering clear interpretation and advice that reflects real-world conditions and operational constraints.
- Compliance-Led Approach: Our testing services support compliance with recognised standards and guidance, including ACoP L8, HSG274 Part 2, HSG282 and HTM 04-01, helping you meet your statutory duties with confidence.
- Fast Turnaround Times: We understand the importance of prompt reporting. Our efficient processes deliver accurate results quickly, supporting swift corrective action where needed.
- Trusted Across Sectors: For over 30 years, Envirochem has supported public and private sector organisations across construction, healthcare, leisure and education, providing reliable microbiological insight and compliance assurance.
Speak to Our Team
If you require microbiological testing to support compliance, assess water quality, or meet the requirements of a Legionella risk assessment, Envirochem’s experts are ready to assist. We’ll help you determine the most appropriate testing suite, sampling approach, and reporting format, ensuring that your facilities remain safe, compliant, and fully informed.
Articles and Research see more articles
Talk to an Expert

-(2)_page-0004.jpg)


